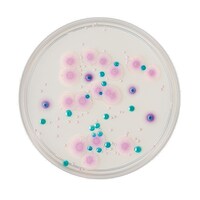
���{�x�N�g���E�f�B�b�L���\���@�a�c�@�a�a�k�i�s�l�j�@�b�g�q�n�l���������i�s�l�j�@�J���W�_�h�h���V�|�n�@�Q�O���@�Q�T�Q�X�T�W�@�P��

日本ベクトン・ディッキンソン BD Difco(TM) ブリリアントグリーン胆汁ブロス2% 500g 274000 培地 その他 1個
水および食品中の大腸菌類の確認検査用培地です。
水および食品中の大腸菌類の確認検査用培地です。+もっと見る
日本ベクトン・ディッキンソン BD Difco(TM) 改良ブリリアントグリーン寒天培地 218801 培地 その他 1個
上下水道および食品中のサルモネラの選択分離培地です。
上下水道および食品中のサルモネラの選択分離培地です。+もっと見る
日本ベクトン・ディッキンソン BD Difco(TM) オックスフォード基礎培地 222530 培地 その他 1個
サプリメントを添加し、リステリア・モノサイトゲネスの選択分離に使用します。
サプリメントを添加し、リステリア・モノサイトゲネスの選択分離に使用します。+もっと見る
日本ベクトン・ディッキンソン BD Difco(TM) ローウェンスタイン基礎培地 244420 培地 その他 1個
抗酸菌の分離および鑑別に使用する基礎培地です。
抗酸菌の分離および鑑別に使用する基礎培地です。+もっと見る
日本ベクトン・ディッキンソン BD Difco(TM) Koserクエン酸培地 215100 培地 その他 1個
クエン酸利用能により大腸菌およびエンテロバクター・アエロゲネスを選択分離する培地です。
クエン酸利用能により大腸菌およびエンテロバクター・アエロゲネスを選択分離する培地です。+もっと見る
日本ベクトン・ディッキンソン BD Difco(TM) 運動性GI培地 286910 培地 その他 1個
受微生物の運動性を検査するための培地です。
受微生物の運動性を検査するための培地です。+もっと見る
日本ベクトン・ディッキンソン BD Difco(TM) 抗生物質培地9(ポリミキシンベース寒天基礎培地) 246210 培地 その他 1個
抗生物質力価検定用培地です。
抗生物質力価検定用培地です。+もっと見る
日本ベクトン・ディッキンソン BD Difco(TM) B12イノキュラムブロス 254210 培地 その他 1個
微生物学的評価法によるビタミンB12の濃度測定に使用します。
微生物学的評価法によるビタミンB12の濃度測定に使用します。+もっと見る
日本ベクトン・ディッキンソン BD Difco(TM) パントテン酸アッセイ培地 260410 培地 その他 1個
微生物学的なパントテン酸塩検査用です。
微生物学的なパントテン酸塩検査用です。+もっと見る
日本ベクトン・ディッキンソン BD Difco(TM) スキムミルク 232100 培地 その他 1個
スプレードライ状で、この10%溶液が同量の新鮮なスキムミルクにあたります。
スプレードライ状で、この10%溶液が同量の新鮮なスキムミルクにあたります。+もっと見る
日本ベクトン・ディッキンソン BD Difco(TM) オックスゲル 212820 分析・検査 培地 1本
脱水させた新鮮胆汁で胆汁耐性細菌の選択に使用します。
脱水させた新鮮胆汁で胆汁耐性細菌の選択に使用します。+もっと見る
日本ベクトン・ディッキンソン BD Difco(TM) 改良オックスフォードサプリメント 1個(6本入) 211763 培地 その他 1個(6本)
改良オックスフォード培地と共に使用します。
改良オックスフォード培地と共に使用します。+もっと見る
Merck ウォーターサンプラー 1袋(25個入) MHPC10025 培地 バイオモニタリング 1袋(25個)
メンブレンフィルターを用いた生菌数検出簡易キットです。
メンブレンフィルターを用いた生菌数検出簡易キットです。+もっと見る
Merck 好気性微生物試験培地 サブローデキストロース寒天培地(クロラモフェニコール入) 30mL 1箱(20枚入) 1.46003.0020
日本薬局方適合の生培地です。
日本薬局方適合の生培地です。+もっと見る
Merck 好気性微生物試験培地 サブローデキストロース寒天培地(クロラモフェニコール入) 30mL 1箱(120枚入) 1.46003.0120
日本薬局方適合の生培地です。
日本薬局方適合の生培地です。+もっと見る
Merck 粉末培地 TSC寒天 ウェルシュ菌分離・計測 1.11972.0500
粉末培地 TSC寒天 ウェルシュ菌分離・計測 は信頼と実績に優れた商品です。
粉末培地 TSC寒天 ウェルシュ菌分離・計測 は信頼と実績に優れた商品です。+もっと見る
Merck 粉末培地 ベアードパーカー寒天培地 Staphylococcus 1.05406.0500
粉末培地 ベアードパーカー寒天培地 Staphylococcus は信頼と実績に優れた商品です。
粉末培地 ベアードパーカー寒天培地 Staphylococcus は信頼と実績に優れた商品です。+もっと見る
ADVANTEC アンプル培地 mEndo(総大腸菌群用)1袋(20個入)
メンブレンフィルターによる微生物試験に用いる、滅菌済みの液体培地です。
メンブレンフィルターによる微生物試験に用いる、滅菌済みの液体培地です。+もっと見る
日本ベクトン・ディッキンソン BD BBL(TM) CHROMagar(TM) カンジダII寒天培地 20枚 252958 1個
BD BBL(TM) CHROMagar(TM) カンジタ寒天培地はC. albicans、C. tropicalis、C. krusei の分離区別のために用いられます。
BD BBL(TM) CHROMagar(TM) カンジタ寒天培地はC. albicans、C. tropicalis、C. krusei の分離区別のために用いられます。+もっと見る
日本ベクトン・ディッキンソン BD BBL(TM) サルモネラ・シゲラ寒天培地 20枚
サルモネラシゲラ寒天培地は、糞便検体からSalmonella、Shigellaの分離培養に適した選択培地です
サルモネラシゲラ寒天培地は、糞便検体からSalmonella、Shigellaの分離培養に適した選択培地です+もっと見る
Merck 粉末培地 (リンゲルタブレット)1箱(100錠入) 1.15525.0001
粉末培地 (リンゲルタブレット)1箱(100錠入) は信頼と実績に優れた商品です。
粉末培地 (リンゲルタブレット)1箱(100錠入) は信頼と実績に優れた商品です。+もっと見る
Merck 粉末培地 (テトラチオネイトブイヨン基礎培地) 500g 1.05285.0500
粉末培地 (テトラチオネイトブイヨン基礎培地) 500g は信頼と実績に優れた商品です。
粉末培地 (テトラチオネイトブイヨン基礎培地) 500g は信頼と実績に優れた商品です。+もっと見る
Merck 粉末培地 (バルカム・リステリア選択基礎培地) 500g 1.11755.0500
粉末培地 (バルカム・リステリア選択基礎培地) 500g は信頼と実績に優れた商品です。
粉末培地 (バルカム・リステリア選択基礎培地) 500g は信頼と実績に優れた商品です。+もっと見る
Merck 粉末培地 (ボルトン選択増菌ブイヨン) 500g 1.00068.0500
粉末培地 (ボルトン選択増菌ブイヨン) 500g は信頼と実績に優れた商品です。
粉末培地 (ボルトン選択増菌ブイヨン) 500g は信頼と実績に優れた商品です。+もっと見る
日本ベクトン・ディッキンソン BD Difco(TM) トリプティックソイ寒天培地 10kg 236930 分析・検査 培地 1個
医薬品品質検査、臨床検査で多く使用される培地です。
医薬品品質検査、臨床検査で多く使用される培地です。+もっと見る
日本ベクトン・ディッキンソン BD Difco(TM) レセーン寒天培地 268010 培地 その他 1個
第四アンモニウム化合物の殺菌活性を調べるテストに用いる培地です。
第四アンモニウム化合物の殺菌活性を調べるテストに用いる培地です。+もっと見る
日本ベクトン・ディッキンソン BD Difco(TM) フェニルアラニン寒天培地 274520 培地 その他 1個
メンブレンフィルター法を使用した腸球菌の選択分離および菌数測定用です。
メンブレンフィルター法を使用した腸球菌の選択分離および菌数測定用です。+もっと見る
日本ベクトン・ディッキンソン BD Difco(TM) ブリューワー嫌気性菌用寒天培地 227920 培地 その他 1個
嫌気性および微好気性微生物の培養に用います。
嫌気性および微好気性微生物の培養に用います。+もっと見る
日本ベクトン・ディッキンソン BD Difco(TM) アジュバント インコンプリートフロイント 1個(6本入) 263910 培地 その他 1個(6本)
フロイントの不完全アジュバントです。結核菌体を含みません。
フロイントの不完全アジュバントです。結核菌体を含みません。+もっと見る
日本ベクトン・ディッキンソン BD Difco(TM) マイコバクテリウムブチリカム粉末 1個(6本入) 264010 分析・検査 培地 1個(6本)
粉末化した不活化済みマイコバクテリウムブチリカムです。
粉末化した不活化済みマイコバクテリウムブチリカムです。+もっと見る
日本ベクトン・ディッキンソン BD BBL(TM) ファイトン酵母エキス寒天培地 211546 1個
皮膚糸状菌、特にTrichophyton verrucosumおよびその他の病原性真菌の選択分離に使用します。
皮膚糸状菌、特にTrichophyton verrucosumおよびその他の病原性真菌の選択分離に使用します。+もっと見る
日本ベクトン・ディッキンソン BD BBL(TM) マンニット食塩寒天培地 20枚
マンニット食塩寒天培地は、Staphylococcus、とくに黄色ブドウ球菌の選択分離に用いられます
マンニット食塩寒天培地は、Staphylococcus、とくに黄色ブドウ球菌の選択分離に用いられます+もっと見る
エルメックス 滅菌液体培地 STSSP
SWAB TESTおよびSwabstar専用のXGAL・MUG培地です。大腸菌群、E.coli検査用です。SWAB TEST、Swabstarの容器内で培養できます。
SWAB TESTおよびSwabstar専用のXGAL・MUG培地です。大腸菌群、E.coli検査用です。SWAB TEST、Swabstarの容器内で培養できます。+もっと見る
Merck 粉末培地 (XLT4寒天基礎培地) 500g 1.13919.0500
粉末培地 (XLT4寒天基礎培地) 500g は信頼と実績に優れた商品です。
粉末培地 (XLT4寒天基礎培地) 500g は信頼と実績に優れた商品です。+もっと見る
Merck 粉末培地 (FDAリステリア増菌ブイヨン) 500g 1.10549.0500
粉末培地 (FDAリステリア増菌ブイヨン) 500g は信頼と実績に優れた商品です。
粉末培地 (FDAリステリア増菌ブイヨン) 500g は信頼と実績に優れた商品です。+もっと見る
日本ベクトン・ディッキンソン BD Difco(TM) MYP寒天培地 281010 培地 その他 1個
EggYolkEnrichment50%およびAntimicrobicVialPを添加して、食物中のセレウス菌の推定に使用します。
EggYolkEnrichment50%およびAntimicrobicVialPを添加して、食物中のセレウス菌の推定に使用します。+もっと見る
日本ベクトン・ディッキンソン BD Difco(TM) マックラング トアベ寒天基礎培地 294110 培地 その他 1個
レシチナーゼ反応に基づいて、食品からクロストリジウム・パーフリンゲンス(ガス壊疽菌)の検出および分離に使用します。
レシチナーゼ反応に基づいて、食品からクロストリジウム・パーフリンゲンス(ガス壊疽菌)の検出および分離に使用します。+もっと見る
日本ベクトン・ディッキンソン BD Difco(TM) 酵母モルフォロジー寒天培地 239320 培地 その他 1個
pHが約4.7に調整された基礎培地を用いた培地です。
pHが約4.7に調整された基礎培地を用いた培地です。+もっと見る
日本ベクトン・ディッキンソン BD Difco(TM) B12培養寒天培地(USP) 254110 培地 その他 1個
微生物学的評価法によるビタミンB12の濃度測定に使用します。
微生物学的評価法によるビタミンB12の濃度測定に使用します。+もっと見る
日本ベクトン・ディッキンソン BD Difco(TM) アジュバント コンプリートH37RA 1個(6本入) 231131 培地 その他 1個(6本)
結核菌体H37Raを含む完全アジュバントです。
結核菌体H37Raを含む完全アジュバントです。+もっと見る
Merck 粉末培地 強化クロストリジウムブイヨン クロストリジウム属、その他嫌気性菌 1.05411.0500
粉末培地 強化クロストリジウムブイヨン クロストリジウム属、その他嫌気性菌 は信頼と実績に優れた商品です。
粉末培地 強化クロストリジウムブイヨン クロストリジウム属、その他嫌気性菌 は信頼と実績に優れた商品です。+もっと見る
アズワン サニスペック粉末培地 標準寒天・顆粒 4112601 培地 1個
アズワンの「サニスペック粉末培地 標準寒天・顆粒」は、品質と信頼性に優れた人気商品です。
アズワンの「サニスペック粉末培地 標準寒天・顆粒」は、品質と信頼性に優れた人気商品です。+もっと見る
アズワン サニスペック粉末培地 ECブイヨン・顆粒 4112610 培地 1個
アズワンの「サニスペック粉末培地 ECブイヨン・顆粒」は、品質と信頼性に優れた人気商品です。
アズワンの「サニスペック粉末培地 ECブイヨン・顆粒」は、品質と信頼性に優れた人気商品です。+もっと見る
アズワン サニスペック生培地 卵黄加マンニット食塩寒天 100枚入 4112753 培地 1箱(100枚入)
培地調製の手間が省け、すぐお使いいただけます。
培地調製の手間が省け、すぐお使いいただけます。+もっと見る
アズワン サニスペック生培地 CP加ポテトデキストロース寒天 100枚入 4112754 培地 1箱(100枚入)
培地調製の手間が省け、すぐお使いいただけます。
培地調製の手間が省け、すぐお使いいただけます。+もっと見る
日本ベクトン・ディッキンソン BD BBL(TM) BTB乳糖加寒天培地 20枚
BTB 乳糖加寒天培地は臨床材料から、特にグラム陰性桿菌の分離用に使用します
BTB 乳糖加寒天培地は臨床材料から、特にグラム陰性桿菌の分離用に使用します+もっと見る
栄研化学 ウサギプラズマ 1箱(5本入) EME07 1箱
黄色ブドウ球菌のコアグラーゼ産生確認用。滅菌生理食塩水7mLで溶解して使用する。
黄色ブドウ球菌のコアグラーゼ産生確認用。滅菌生理食塩水7mLで溶解して使用する。+もっと見る